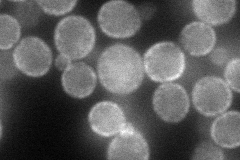
YOL130W
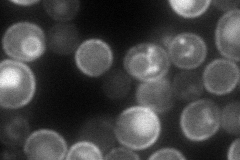
YOL130W
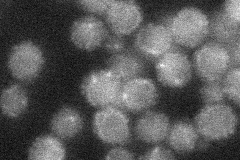
YOL130W
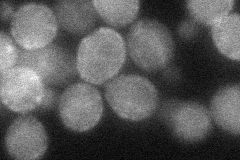
YOL130W
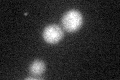
YOL130W
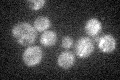
YOL130W

View description
Plasma membrane Mg(2+) transporter, expression and turnover are regulated by Mg(2+) concentration; overexpression confers increased tolerance to Al(3+) and Ga(3+) ions
Localization:
Intensity:
Fold change:
Significance:
-
C’ GFP library in SD

below threshold16.87 -
N' NOP1pr-GFP in SD
cell periphery88.0694 -
N' TEF2pr-mCherry in SD
cell periphery,vacuole92.3605 -
N' NATIVEpr-GFP in SD
cell periphery,punctate24.6028 -
N' TEF2pr-VC and Cyto-VN in SD
cell periphery,punctate41.7387 -
C’ GFP library in SD+DTT
cytosol15.680.92No -
C’ GFP library in SD+H2O2
cytosol17.11.01No -
C’ GFP library in Starvation Media

cytosol18.831.11No -
C’ GFP library on the background of Pup2-DaMP

below threshold -
C’ GFP library on the background of CCT mutant

below threshold15.73980.93283No
